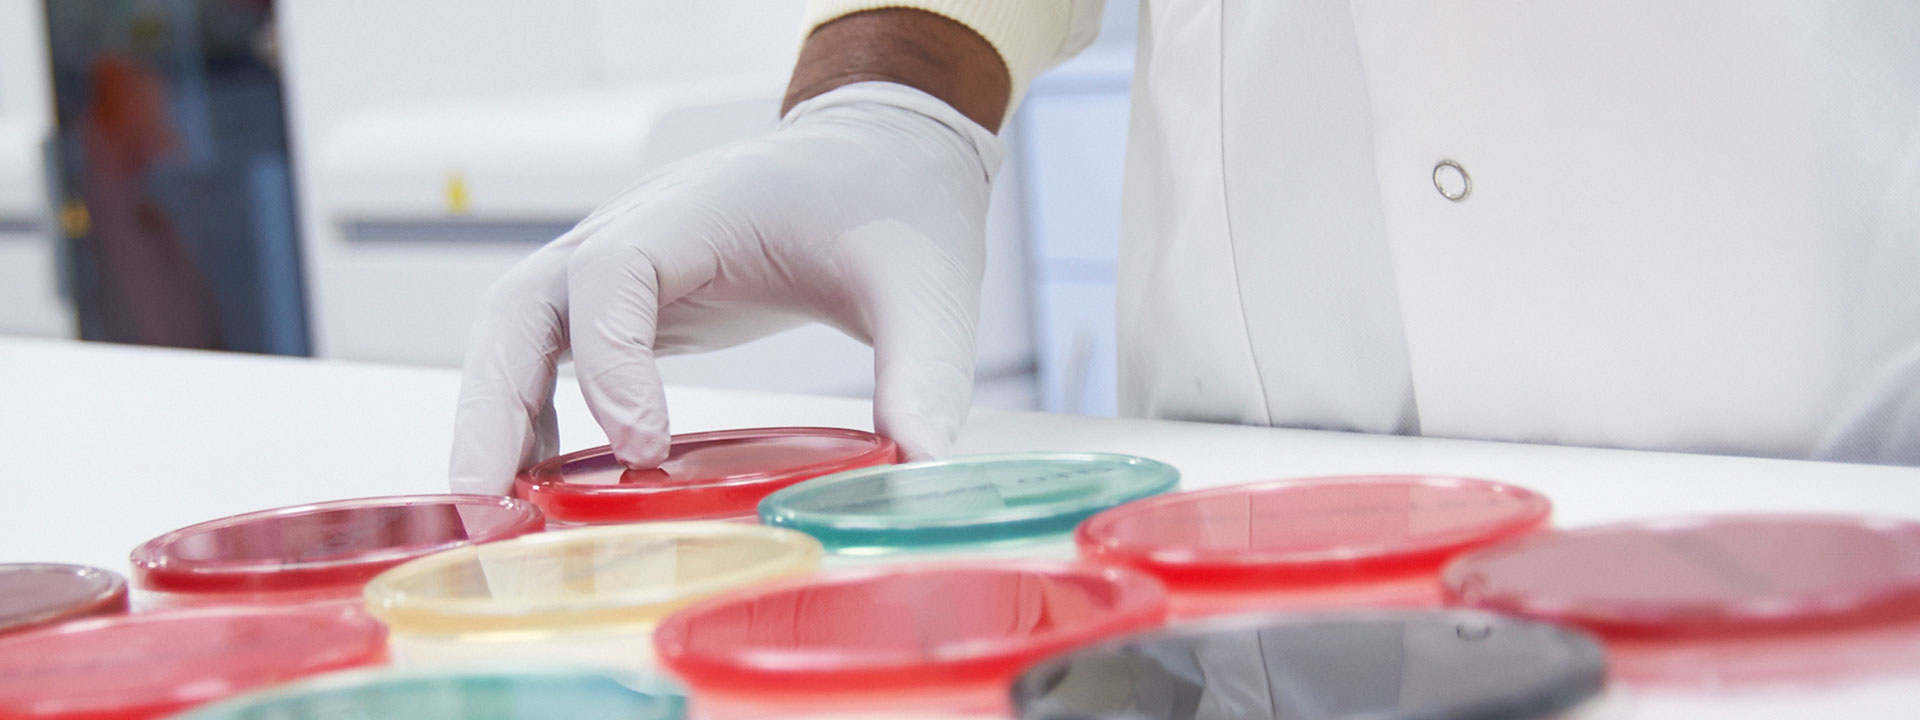
h-002

About Us
Proteus Laboratories was established 15 years ago
Our Work
How Laboratory Works
Sample Collections
Samples of blood , urine and swabs are collected from all sites and Doctors and delivered to the laboratory for testing .

Sample Testing
All sample are tested according to required test 24 / 7 and sent for verification..

Result Verification
Verification is done and test results are sent back to Doctors and private walk in clients via email.
